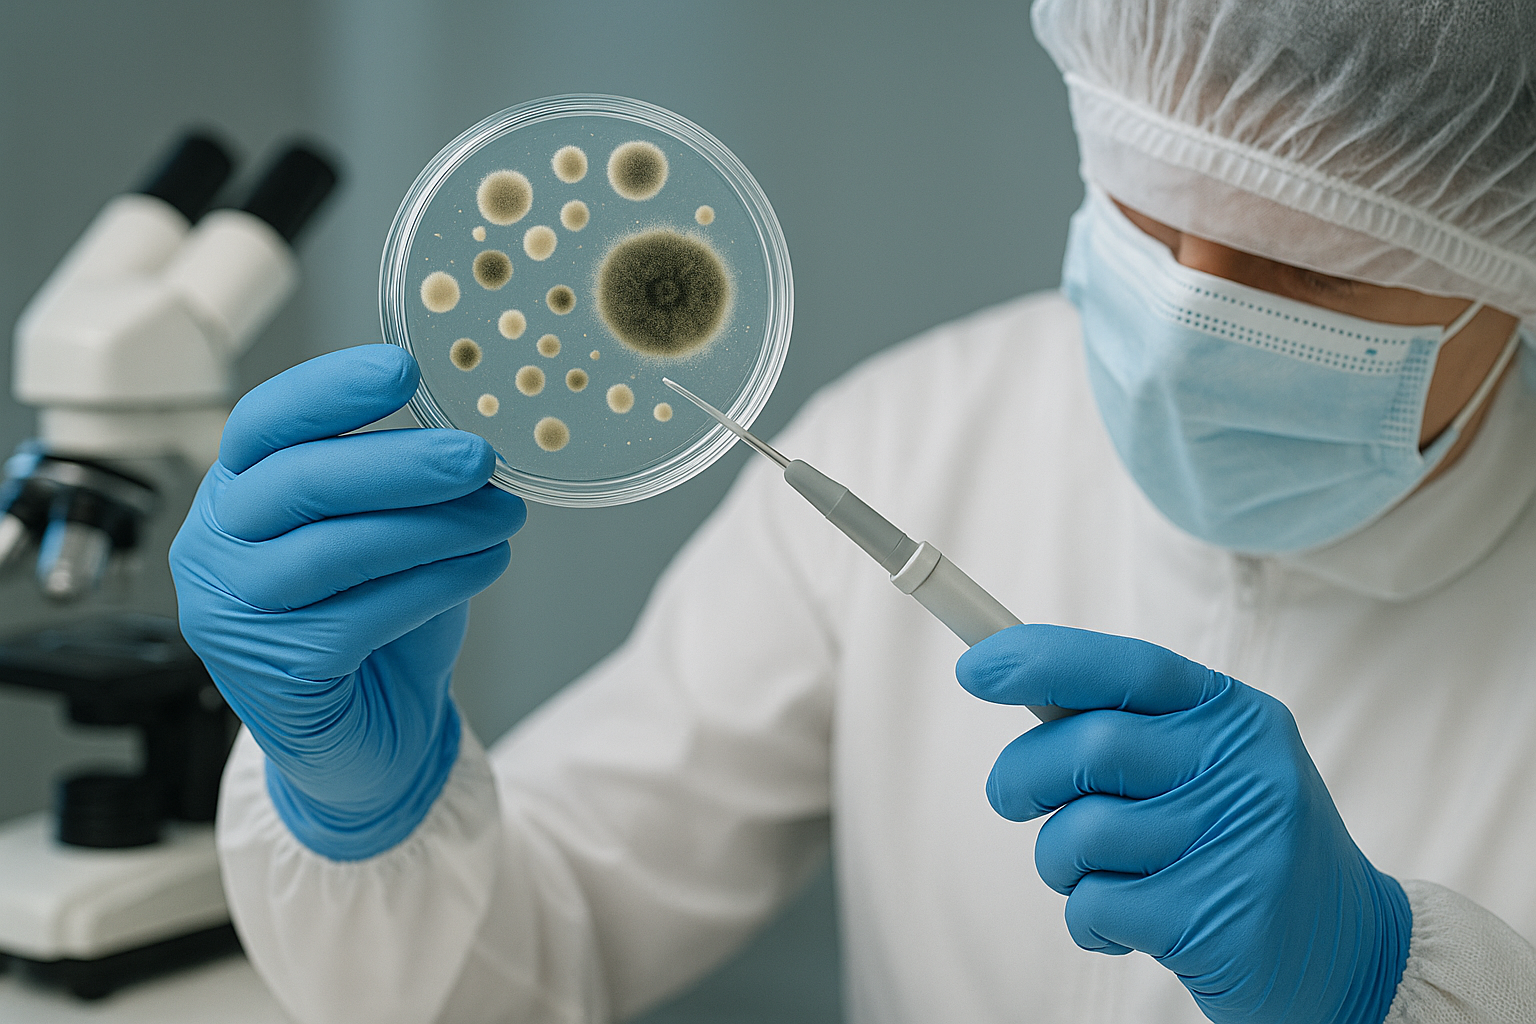

When it comes to protecting your home and health, mold is about as sneaky and frustrating as it gets—it thrives in our hot, humid Florida climate, and often hides in places you can’t easily see. If you’ve walked down the home improvement aisle recently, you’ve probably noticed DIY mold test kits that promise quick answers for a low price, and it can feel tempting to toss one in your cart, especially if you suspect a problem.
But here’s the truth: DIY mold kits don’t give you the reliable, actionable information you need. At best, they confirm that mold spores are present (which is almost always the case), and at worst, they provide misleading results that delay proper treatment. In this blog, we’ll bust some of the biggest myths about store-bought mold kits and explain why professional testing is the only way to truly protect your home and health.
The Most Common Mold Myths
Myth #1: “A DIY Kit Will Tell Me If I Have Mold”
The packaging on most store kits makes it seem like you’ll get a simple “yes or no” answer. But the problem is that mold spores are everywhere. They float through the air naturally, indoors and outdoors. So when you set out a petri dish or swab a surface, you’re almost guaranteed to see growth.
This doesn’t mean you have a mold problem. It just means you live in the real world, where mold exists. The real question isn’t whether spores are present, but whether you have elevated levels of harmful mold, where it’s concentrated, and how it’s impacting your air quality. A DIY kit can’t answer any of that.
Myth #2: “The Kit Will Tell Me What Kind of Mold I Have”
Some kits advertise that you can send your sample to a lab for identification. This may sound promising, but the results often don’t provide the context you need. Knowing the species of mold doesn’t tell you if it’s dangerous in your specific environment.
For example, you might see Aspergillus or Cladosporium, two very common mold types, on your report. But without professional interpretation, you won’t know if the levels found are typical background amounts or a sign of an active infestation that requires remediation.
A certified inspector doesn’t just list mold species; they analyze air samples, compare indoor and outdoor readings, and provide insight into whether the growth is a health risk or a normal occurrence. That’s the difference between data and diagnosis.
Myth #3: “A Kit Will Show Me Where the Mold Is Coming From”
Mold isn’t always visible. You might smell a musty odor but see nothing on your walls or ceilings. DIY kits can’t pinpoint hidden growth behind drywall, under flooring, in attics, or inside your HVAC system.
Professional testing, on the other hand, involves air sampling, moisture mapping, and thermal imaging tools that detect mold at its source. This matters because successful remediation depends on eliminating the cause of the problem, often a hidden leak, condensation issue, or poor ventilation. Without addressing the root cause, mold will just keep coming back.
Myth #4: “DIY Kits Save Money Compared to Professional Testing”
At first glance, a $10–$50 test kit looks like a bargain compared to professional services. But here’s the catch: inaccurate or incomplete results can actually cost you more in the long run.
- False peace of mind: You might believe your home is safe when mold is still spreading out of sight.
- Unnecessary panic: You may spend money on ineffective DIY cleaning methods because the kit made the problem seem worse than it is.
- Delayed action: Waiting until the issue becomes severe can lead to more expensive remediation and repairs later.
When you invest in professional testing, you’re paying for accuracy, expertise, and peace of mind. It’s the difference between guessing and knowing.
Myth #5: “I Can Just Handle Mold Cleanup Myself”
Even if a kit confirms mold, it doesn’t tell you the scale of the problem, or whether it’s safe to handle on your own. Small patches of surface mold (like mildew in the shower) are often manageable with cleaning. But larger infestations, or mold caused by water damage, require specialized equipment and containment to ensure spores don’t spread throughout the house.
Professional inspectors and remediators follow industry standards (like IICRC S520) to ensure mold is removed safely and completely. Attempting cleanup without this knowledge can expose you and your family to health risks and cross-contamination.
The Value of Professional Mold Testing
So what does professional mold testing offer that DIY kits don’t?
- Comprehensive assessment – Certified inspectors evaluate your entire home, not just a single sample spot.
- Air quality testing – By comparing indoor and outdoor spore counts, pros can determine if mold is elevated beyond normal levels.
- Source identification – Tools like moisture meters and infrared cameras locate the root cause of hidden mold.
- Actionable reports – Instead of just listing mold types, you’ll get a clear explanation of what the results mean for your home and health.
- Trusted solutions – If remediation is necessary, testing guides the process and verifies success once cleanup is complete.
Protecting Your Home and Health
Simply put, DIY mold kits can’t give you the clarity you need to make informed decisions. They provide incomplete or misleading results, and they can’t replace the knowledge and tools that come with professional testing.
If you’re dealing with musty odors, unexplained health symptoms, or visible mold, don’t waste time (and money) on a store-bought kit. Instead, reach out to a certified professional who can provide reliable testing, identify the source of the problem, and recommend the right next steps.
Your home is one of your biggest investments, and your health is priceless. Make sure both are protected with the professional care they deserve. At All Pride Environmental & Restoration, we know how Florida’s climate creates the perfect breeding ground for mold. Our certified team uses industry-leading testing methods to uncover the source of mold problems and provide clear solutions that protect your home and your family.
Contact us today to schedule your professional mold inspection.

.png)
.png)




.png)